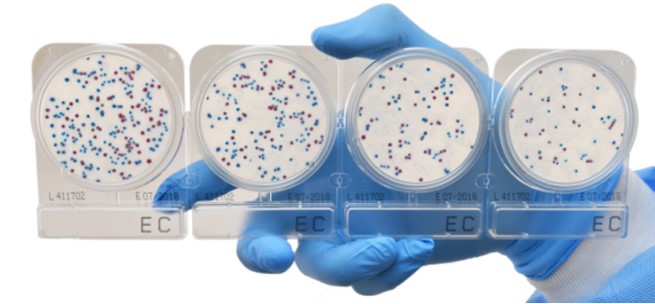
Compact Dry EC (สำหรับตรวจ E.coli และ Coliform)
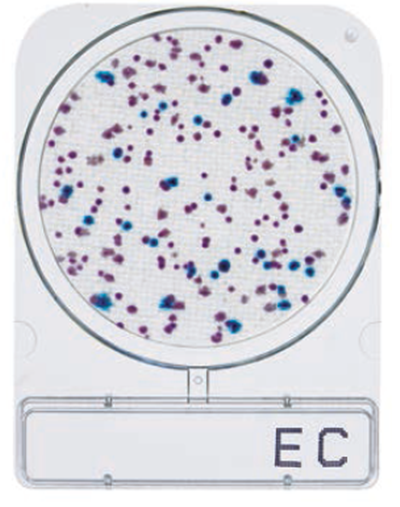
Compact Dry EC (สำหรับตรวจ E.coli และ Coliform)

Compact Dry EC (สำหรับตรวจ E.coli และ Coliform)
รหัสสินค้า 89-1-NIS-EC
{{show_pdata.before_vat_price_text}} (ยังไม่รวม Vat)
2,675.00 - 12,840.00 บาท
ราคาปกติ บาท
| จำนวน{{focus_pdata.unit}} | ส่วนลดต่อ{{focus_pdata.unit}} | ราคาสุทธิต่อ{{focus_pdata.unit}} |
| {{(typeof focus_pdata.price_list[idx+1] == 'undefined')?('≥ '+price_row.min_quantity):((price_row.min_quantity < (focus_pdata.price_list[idx+1].min_quantity - 1))?(price_row.min_quantity+' - '+(focus_pdata.price_list[idx+1].min_quantity - 1)):price_row.min_quantity)}} | {{number_format(((focus_pdata.price_old === null)?focus_pdata.price:focus_pdata.price_old) - price_row.price,2)}} บาท | {{number_format(price_row.price,2)}} บาท |
| {{ sub_option.name }} | - ไม่มีตัวเลือก - |
|
| คงเหลือ | 4 กล่อง | |
| จำนวน (กล่อง) |
- +
|
|
|
ซื้อเลย หยิบลงตะกร้า ซื้อเลย หยิบลงตะกร้า คุณมีสินค้าชิ้นนี้ในตะกร้า 0 กล่อง
|
||
|
|
||
| คุยกับร้านค้า | ||
| {{ size_chart_name }} |
|
|
| หมวดหมู่ | Compact Dry ตลับเพลทอาหารเลี้ยงเชื้อสำเร็จรูป | |
| สภาพ | สินค้าใหม่ | |
| เพิ่มเติม | ||
| สภาพ | สินค้ามือสอง | |
| เกรด | ||
| สถานะสินค้า | ||
| ระยะเวลาจัดเตรียมสินค้า | ||
| เข้าร่วมโปรโมชั่น | ||
*ราคาสินค้ารวมภาษีมูลค่าเพิ่ม (vat 7 %) แล้ว
วิธีการส่งสินค้า
| สินค้า | ราคา (รวมvat) | เงื่อนไข |
| สินค้าปกติ |
107 บาท |
สั่งซื้อ 3,000 บาทขึ้นไปส่งฟรี |
| สินค้าแช่เย็น | 214 บาท |
ทุกคำสั่งซื้อ |
*สินค้าที่ต้องแช่เย็น เช่น ชุดทดสอบหายาฆ่าแมลง, ชุดทดสอบสารก่อภูมิแพ้ เป็นต้น ซึ่งจะมีระบุอยู่ที่เงื่อนไขอื่นๆด้านล่างหน้าสินค้านั้นนะคะ
*โปรดเลือกวิธีการส่งให้ตรงกับสินค้าที่ซื้อ มิฉะนั้นจะไม่สามารถทำการจัดส่งสินค้าให้ได้ค่ะ
รายละเอียดสินค้า
| ข้อมูล |
น้ำหนัก
บาร์โค้ด
ลงสินค้า
อัพเดทล่าสุด
|
| รายละเอียดสินค้า |
Compact Dry EC (สำหรับตรวจ E.coli และ Coliform)
เพลทเลี้ยงเชื้อสำเร็จรูปตรวจหาเชื้ออี.โคไลและโคลิฟอร์มคำอธิบาย
เป็นจานอาหารเลี้ยงเชื้อสำเร็จรูป สำหรับตรวจ E.coli และ Coliform ประกอบด้วยอาหารเลี้ยงเชื้อแบบ Selective มีการเติม Chromogenic enzyme substrate 2 ชนิดคือ X-Gluc ทำปฏิกิริยากับ เอนไซม์ β-glucuronidase ทำให้โคโลนี E.coli มีสีน้ำเงิน และ Magenta-GAL ทำปฏิกิริยากับ β-galactosidase ให้โคโลนี Coliform เป็นสีม่วงสามารถรายงานผลการทดสอบได้รวดเร็วภายใน 24 ชั่วโมง
คุณสมบัติ
ข้อมูลจำเพาะ
APPROVED
PACKAGE
compactdry ec, compact dry e.coli, e coli coliform test kit, ec rapid test plate, ec bacteria detection, คอมแพคดราย EC, ชุดตรวจอีโคไล, ตรวจเชื้ออีโคไลและโคลิฟอร์ม, กระดาษทดสอบ e.coli, เพลทตรวจ e.coli |
| เงื่อนไขอื่นๆ |
|
| Tags |
วิธีการชำระเงิน
ชำระเงินผ่านธนาคาร
ชำระเงินด้วยการ Scan QR



บริษัท บี สมาร์ท ซายเอ็นซ์ จำกัด
012-xxxxxx-2
Accept All Banks | รับเงินได้จากทุกธนาคาร
นโยบายการเปลี่ยนหรือคืนสินค้า
เงื่อนไขการเปลี่ยน/คืนสินค้า
หากสินค้ามีปัญหากรุณาติดต่อมาที่ Line ID : @bsma หรือ โทร 02-4493941
- บริษัทฯ ยินดีรับเปลี่ยน/คืนสินค้า ภายใน 7 วันทำการนับตั้งแต่ลูกค้าเซ็นรับสินค้า หากเกินจากวันเวลาดังกล่าว บริษัทฯ ขอสงวนสิทธิ์ในการไม่รับเปลี่ยน/คืนสินค้า
- ทางบริษัทขอสงวนสิทธิ์ในการไม่รับเปลี่ยนสินค้าคืนทุกกรณี เช่น ลูกค้าไม่พึงพอใจในตัวผลิตภัณฑ์สินค้า ลูกค้าต้องการเปลี่ยนสินค้าข้ามรุ่น หรือลูกค้าสั่งซื้อสินค้าผิด
- ลูกค้าจะต้องถ่ายวิดิโอขณะแกะกล่องพัสดุ แบบคลิปเดียวจบ ไม่มีตัดต่อ หากไม่มีวิดิโอยืนยัน บริษัทฯ ขอสงวนสิทธิ์ในการไม่รับเปลี่ยน/คืนสินค้า
- ลูกค้าจะต้องทำการจัดส่งสินค้ากลับมายังบริษัทฯ โดยที่สินค้าที่ต้องการเปลี่ยน/คืนจะต้องอยู่ในสภาพสมบูรณ์ ไม่ชำรุดเสียหายจากการใช้งาน
- บริษัทฯ ขอสงวนสิทธิ์ในการพิจารณาตรวจสอบสภาพสินค้าที่ลูกค้าส่งกลับคืนมาก่อนจัดส่งสินค้าชิ้นใหม่ให้แก่ลูกค้า
- บริษัทฯ ขอสงวนสิทธิ์ในการรับเปลี่ยนสินค้าภายใต้นโยบายและเงื่อนไขตามที่บริษัทฯ กำหนดเท่านั้น
- สินค้าผิดรุ่น สินค้าผิดสี สินค้าไม่ตรงตามสเปค
- สินค้ามีสภาพชำรุด เสียหาย หรือไม่สามารถใช้งานได้ตั้งแต่ได้รับสินค้า
หากสินค้ามีปัญหากรุณาติดต่อมาที่ Line ID : @bsma หรือ โทร 02-4493941
กรุณาเลือกแบบสินค้าก่อนสั่งซื้อ
Compact Dry EC (สำหรับตรวจ E.coli และ Coliform)
ราคาปกติ บาท
| - ไม่มีตัวเลือก - |
|
|
| คงเหลือ | 4 กล่อง | |
| จำนวน (กล่อง) |
- +
|
|
|
ไม่มีสินค้าที่เลือก
กรุณาเลือกแบบสินค้าก่อนสั่งซื้อ
ซื้อเลย หยิบลงตะกร้า คุณมีสินค้าชิ้นนี้ในตะกร้า 0 กล่อง
|
||
Related to items you've viewed
Your recently viewed items
 บริษัท บี สมาร์ท ซายเอ็นซ์ จำกัด
บริษัท บี สมาร์ท ซายเอ็นซ์ จำกัด
{{is_joined?'เป็นสมาชิกแล้ว':'Join เป็นสมาชิกร้าน'}}
384
สมัครสมาชิกร้านนี้ เพื่อรับสิทธิพิเศษ
ร้านค้าออนไลน์
Inspired by
LnwShop.com (v2)
▲
▼
รายการสั่งซื้อของฉัน
รายการสั่งซื้อของฉัน
ข้อมูลร้านค้านี้

บริษัท บี สมาร์ท ซายเอ็นซ์ จำกัด
ศูนย์รวม เครื่องมือ เคมีภัณฑ์ อุปกรณ์วิทยาศาตร์ ชุดทดสอบสารปนเปื้อนใน อาหาร น้ำ ยา ดิน เครื่องสำอาง เพื่อใช้ในห้องแล็บ โรงงานอุตสาหกรรม ด้านเกษตร การเรียนการสอนในโรงเรียน งานราชการ เอกชน และ ประชาชนทั่วไป
เบอร์โทร : 02-4493941
อีเมล : bsmartsci@gmail.com
อีเมล : bsmartsci@gmail.com
ส่งข้อความติดต่อร้าน
เกี่ยวกับร้านค้านี้
ค้นหาสินค้าในร้านนี้
ค้นหาสินค้า
สินค้าที่ดูล่าสุด
บันทึกเป็นร้านโปรด
Join เป็นสมาชิกร้าน
แชร์หน้านี้
แชร์หน้านี้
↑
TOP เลื่อนขึ้นบนสุด
TOP เลื่อนขึ้นบนสุด
คุณมีสินค้า 0 ชิ้นในตะกร้า สั่งซื้อทันที
สินค้าในตะกร้า ({{total_num}} รายการ)

ขออภัย ขณะนี้ยังไม่มีสินค้าในตะกร้า
ราคาสินค้าทั้งหมด
฿ {{price_format(total_price)}}
- ฿ {{price_format(discount.price)}}
ราคาสินค้าทั้งหมด
{{total_quantity}} ชิ้น
฿ {{price_format(after_product_price)}}
ราคาไม่รวมค่าจัดส่ง
รวมภาษีมูลค่าเพิ่มแล้ว
➜ เลือกซื้อสินค้าเพิ่ม



